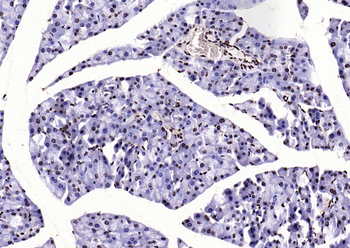
Histone H3 (di methyl K36) Mouse Monoclonal Antibody

You have no items in your shopping cart.
All Products
- Melatonin Receptor 1A antibody [orb11085]Featured

ELISA, ICC, IF, IHC-P, WB
Rabbit
Polyclonal
Unconjugated
100 μg - PKM Antibody [orb688873]
ELISA, FC, IF, IHC, IP, WB
Human, Mouse
Mouse
Monoclonal
Unconjugated
100 μl, 50 μl - ACTB Rabbit Polyclonal Antibody [orb577463]
IHC, WB
Human, Mouse
Bovine, Equine, Goat, Porcine, Rat, Sheep, Zebrafish
Rabbit
Polyclonal
Unconjugated
100 μl - Featured

ELISA, IF, IHC-Fr, IHC-P, WB
Human, Mouse, Rat
Hamster
Rabbit
Polyclonal
Unconjugated
1 ml, 100 μl, 500 μl, 200 μl - MBP Rabbit Polyclonal Antibody [orb11027]Featured

IF, IHC-Fr, IHC-P, WB
Human, Mouse, Rat
Bovine, Canine, Equine, Porcine, Rabbit, Sheep
Rabbit
Polyclonal
Unconjugated
50 μl, 100 μl, 200 μl - Notch1 Rabbit Polyclonal Antibody [orb500788]Featured

IF, IHC-Fr, IHC-P, WB
Human, Mouse, Rat
Mouse, Rat
Rabbit
Polyclonal
Unconjugated
100 μl, 50 μl, 200 μl - Featured

IF, IHC-Fr, IHC-P
Human, Mouse, Rat
Mouse, Rat
Mouse
Monoclonal
Unconjugated
200 μg, 100 μl, 50 μl, 200 μl - Featured

FC, ICC, IF, IHC-Fr, IHC-P
Human, Mouse, Rat
Bovine, Canine, Equine, Gallus, Guinea pig, Porcine, Rabbit
Rabbit
Polyclonal
Unconjugated
50 μl, 100 μl, 200 μl - NFKB p65 Rabbit Polyclonal Antibody [orb11118]Featured

FC, ICC
Human, Mouse
Bovine, Canine, Equine, Gallus, Porcine, Rabbit, Rat, Sheep, Zebrafish
Rabbit
Polyclonal
Unconjugated
50 μl, 100 μl, 200 μl - Collagen Type I Antibody [orb345345]
DOT, ELISA, FLISA, IHC, IP, WB
Bovine, Human, Mouse, Porcine, Rat
Rabbit
Polyclonal
Unconjugated
25 μl